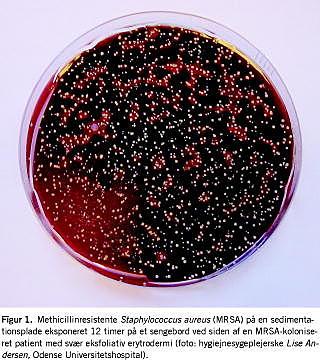

Snavs er uæstetisk, men øger det også risikoen for hospitalsinfektioner? Spørgsmålet er blevet tiltagende aktuelt i de senere år, hvor hospitalsdriften er intensiveret, samtidig med at rengøringen mange steder har været udsat for store besparelser. Resultatet er, at de fleste hospitaler i dag fremstår mere snavsede end tidligere. Udviklingen er ikke enestående for Danmark, men gælder for hele den vestlige verden [1].
Sammenhængen mellem snavs i hospitalsmiljøet og forekomsten af hospitalsinfektioner er ikke entydig, men der er nogen dokumentation for, at en sådan sammenhæng rent faktisk eksisterer: Patienter og personale udskiller mikroorganismer (MO) til hospitalsmiljøet, hvor de samler sig i støv og snavs på bl.a. senge, sengeborde, stole, dørhåndtag, håndvaske og toiletter. Herfra vil de kunne overføres til patienter ved direkte kontakt med berøringsflader eller ved indirekte kontakt via personalets hænder og uniformer. Hvis kontamineringen bliver tilstrækkelig stor, vil smitte også kunne udbredes luftbårent gennem ophvirvlet støv.
I denne artikel har vi gennemgået litteraturen mhp. at belyse, om patienter kan smittes med MO fra støv og snavs i hospitalsmiljøet, om rengøring kan eliminere eller nedbringe mængden af potentielt patogene MO i miljøet, og om dette fører til en reduktion i antallet af hospitalsinfektioner forårsaget af MO. Vi har valgt at begrænse analysen til MO, som kan tåle udtørring og overleve i længere tid uden for værtsorganismen, og som samtidig er vigtige årsager til hospitalsinfektioner. Det drejer sig om: Staphylococcus aureus, herunder methicillinresistente (MRSA), Clostridium difficile, Acinetobacter baumannii, enterokokker og Norovirus.
Metode
Litteratursøgningen blev foretaget i PubMed-databasen med flg. begrænsninger: only items with abstracts, English, Danish og humans. De anvendte søgeord var hospital cleaning, nosocomial infection og hospital cleaning, surface hygiene. Abstrakter på de ved søgningen fundne artikler blev herefter gennemgået. De artikler, der omhandlede de relevante MO, og hvori rengøring af hospitalsmiljøet indgik som et centralt element, blev udvalgt. Ved gennemgang af de udvalgte artiklers litteraturlister blev der fundet supplerende litteratur (snowball -metoden). Pga. meget få artikler om Norovirus blev der ved yderligere søgning anvendt ordene: Norwalk agent og environmental contamination.

Resultater
Staphylococcus aureus
Man har i adskillige studier påvist, at patienter med MRSA kan udskille store mængder bakterier til hospitalsmiljøet. Risikoen er særlig stor hos patienter med kroniske hudlidelser (Figur 1 ), sårinfektioner og urin- og luftvejsinfektioner. I enkelte studier har man dokumenteret, at MRSA fra miljøet kan transmitteres til personale og patienter og give anledning til nye infektioner, men der er kun ganske få interventionsstudier, hvori man dokumenterer effekten af rengøring. Den er bedst belyst af Rampling et al, som kunne standse et langvarigt MRSA-udbrud på et urologisk sengeafsnit ved at reorganisere og intensivere rengøringen. Tiden til rengøring blev fordoblet, og interventionen fokuserede på fjernelse af støv med støvsugere forsynet med bakteriefilter og afspritning af utensilier som supplement til den almindelige rengøring med sæbe og vand [2]. Sidstnævnte fjerner ikke MRSA fra miljøet. French et al påviste således, at MRSA var til stede i miljøet i 74% af prøver før rengøring og i 66% efter almindelig våd rengøring med sæbe og vand. Dekontaminering af sengestuer med H2 O2 -holdig damp var langt mere effektiv, idet der efterfølgende kun blev påvist MRSA i 1% af de undersøgte miljøprøver [3].
Clostridium difficile
Clostridium difficile (CD) er en hyppig årsag til antibiotikaassocieret diare hos indlagte patienter. Bakterien er sporedannende, og inficerede patienter udskiller sporer i stort tal til hospitalsmiljøet, hvor sporerne kan overleve i månedsvis. Wilcox et al sammenlignede effekten af desinficerende rengøring med hypochlorit og almindelig rengøring uden desinfektionsmiddel i et prospektivt overkrydsningsstudie: De påviste, at rengøring med hypochlorit reducerede forekomsten af CD i miljøet og hyppigheden af hospitalserhvervet CD-infektion på en afdeling, hvor CD var højendemisk (8,9 tilfælde pr. 100 indlæggelser). Interventionen var derimod uden effekt på en anden afdeling, hvor forekomsten var lav (3,5 tilfælde pr. 100 indlæggelser) [4]. Mayfield et al sammenlignede effekten af desinficerende rengøring med hypochlorit og kvartær ammoniumforbindelse i et før- og efter-interventionsstudie i en knoglemarvstransplantationsenhed, hvor CD var højendemisk. Intervention med hypochlorit reducerede forekomsten af CD-infektioner fra 8,6 til 3,3 pr. 1.000 patientdage, og ved tilbagevenden til kvartær ammoniumforbindelse steg forekomsten til 8,1. Interventionen havde ingen effekt på to andre afdelinger, hvor forekomsten af CD var lav [5].
Acinetobacter baumannii
Multiresistente Acinetobacter baumannii (AB) selekteres med bredspektrede antibiotika og er især et problem på intensivafdelinger. Bakterien tåler udtørring gennem uger til måneder og ophobes i støv ligesom stafylokokker. I flere studier har man påvist, at AB er massivt til stede i hospitalsmiljøet under udbrud, og at koncentrationen korrelerer med antallet af inficerede patienter. Desinficerende rengøring med hypochlorit reducerer kontamineringen af miljøet, og enkelte observationer tyder på, at det også reducerer forekomsten af AB-infektioner [6].
Enterokokker
Enterokokker udskilles fra patienter og findes i hospitalsmiljøet især på intensivafdelinger og hæmatologiske afdelinger, hvor de selekteres ved et højt forbrug af cefalosporiner og andre bredspektrede antibiotika. Vancomycinresistente enterokokker (VRE) er et stort problem i udlandet, men forekommer kun sporadisk i Danmark. Man har i flere studier påvist, at patienter kan smittes med VRE fra hospitalsmiljøet, og resultaterne af enkelte studier tyder på, at opprioriteret rengøring, herunder brug af desinfektionsmidler, medvirker til at begrænse infektionsudbrud. Resultaterne er dog langtfra entydige, og fortolkningen vanskeliggøres af, at rengøring i de fleste tilfælde blot er et enkelt led i en flerstrenget intervention. Intensiv rengøring med kv artære ammoniumforbindelser kan effektivt eliminere VRE fra kontaminerede overflader [7].
Norovirus
Norovirusinfektion er karakteriseret ved eksplosive opkastninger og diare, og infektionsudbrud medfører derfor ofte en kraftig kontaminering af hospitalsmiljøet. Virus tåler udtørring og kan overleve i f.eks. gulvtæpper, hvor det bevarer sin infektivitet i op til et par uger. Smitte fra miljøet er dokumenteret. Desinficerende rengøring med hypochlorit har i modelforsøg vist sig at være effektivt til elimination af virus fra kontaminerede overflader, men der er ingen dokumentation for, at det virker i klinikken og forebygger smittespredning [8]. Konventionel rengøring og støvsugning har ingen effekt.
Diskussion
Rengøring kan opdeles i mekanisk rengøring, dvs. bortfjernelse af snavs vha. støvsugning og vask med vand sæbe, og desinficerende rengøring med brug af et desinfektionsmiddel. Denne skelnen er vigtig, fordi mekanisk rengøring ikke nødvendigvis nedbringer antallet af MO i miljøet. MO forekommer i støv, så mekanisk fjernelse af dette hindrer ophvirvlen og spredning, men mekanisk rengøring herunder specielt våd rengøring medfører også risiko for udsæd og spredning af MO fra kontaminerede til ikkekontaminerede områder. En forudsætning, for at forekomsten af en given MO i miljøet fører til infektion, er naturligvis, at MO overføres til patienten. En sådan overførsel kan ske direkte eller indirekte og indebærer, at det ikke nødvendigvis er kontamineringens størrelse, men måske snarere dens lokalisation, der har betydning. Selv et større reservoir på eksempelvis gulvet er derfor teoretisk mindre problematisk end forekomst på genstande i patientens umiddelbare miljø, fordi patienten ikke nødvendigvis kommer i kontakt med gulvet. Et kontamineret sengegærde, et bord, en stikkontakt, en vandhane etc. berøres derimod af patienter og af personale, der er i fysisk kontakt med patienter, og er derfor potentielt farligere. Desinfektionsmidler kan fjerne denne kontaminering, men medfører også en række problemer af miljø- og arbejdsmiljømæssig karakter.
Selv om det er nærliggende at forestille sig, at snavsede hospitaler kan medføre infektioner, er området uudforsket. Antallet af foreliggende studier er sparsomt, og de er ikke udført efter en ensartet fremgangsmåde. I de fleste beskrives, hvorledes en samlet strategi, hvori rengøring indgår som et af flere elementer, kan bringe udbrud af en given mikroorganisme til ophør. Rengøringens relative vægt i den samlede strategi er generelt dårligt belyst. Studierne er ofte af kort varighed, og langtidseffekten er derfor dårligt belyst. Der er dog grund til at hæfte sig ved, at intensiveret rengøring kan medvirke til effektivt at dæmme op for spredning af stafylokokinfektioner, herunder MRSA, og infektioner med CD [2, 4, 5]. Dette er specielt vigtigt set i lyset af, at vi de seneste år har haft stigende forekomst af MRSA i Danmark, både i og uden for hospitaler. Der er derfor et påtrængende behov for at styrke den infektionsforebyggende indsats mhp. at forebygge MRSA-spredning på hospitaler og i institutioner.
Rengøring har i mange år været et hygiejnisk forsømt område. Det faglige ansvar for rengøringen ligger ikke i hygiejneorganisationerne, men i hospitalernes driftsafdelinger, og arbejdet udføres af personale med begrænset infektionshygiejnisk indsigt. Der fokuseres primært på æstetiske forhold, og de rutinemæssigt anvendte rengøringsmetoder, som primært er dikteret af rationalitetshensyn, reducerer ikke forekomsten af sygdomsfremkaldende MO i hospitalsmiljøet [3]. Der er et stort behov for mere forskning inden for rengøringsområdet med fokus på nedbringelse af bakteriekoncentrationen i miljøet. Specielt er der brug for at afprøve nye rengøringsstrategier, som tager sigte på at fjerne støv og reducere kontamineringen på genstande og flader, som hyppigt berøres af patienter og personale. Relevante eksempler kunne være brug af støvsugere med bakterietætte filtre og målrettet anvendelse af desinfektionsmidler på dørhåndtag og andre særligt udsatte berøringsflader. Herudover er der brug for nye standarder og indikatorer til måling af den hygiejniske kvalitet af rengøringen [9, 10].
Selv om dokumentationen fortsat er ufuldstændig, viser de senere års forskning, at desinficerende rengøring kan have en infektionsforebyggende effekt over for visse mikroorganismer, specielt MRSA og CD. Resultaterne af fremtidig forskning må afgøre nærmere, hvilken rolle rengøring har i infektionsforebyggelsen på hospitalerne. Driftsafdelinger og hygiejneorganisationer bør indlede samarbejde mhp. at optimere rengøringsmetodernes hygiejniske aspekter og dokumentere deres infektionsforebyggende effekt.
Hans Jørn Kolmos, Klinisk Mikrobiologisk Afdeling, Odense Universitetshospital, DK-5000 Odense C.
E-mail: hans.joern.kolmos@ouh.regionsyddanmark.dk
Antaget: 20. august 2007
Interessekonflikter: Ingen angivet
<ol class="Litt-list">
<li>Dancer SJ. Mopping up hospital infection. J Hosp Infect 1999;43:85-100.</li>
<li>Rampling A, Wiseman S, Davis L et al. Evidence that hospital hygiene is important in the control of methicillin-resistant Staphylococcus aureus. J Hosp Infect 2001;49:109-16.</li>
<li>French GL, Otter JA, Shannon KP et al. Tackling contamination of the hospital environment by methicillin-resistant Staphylococcus aureus (MRSA): a comparison between conventional terminal cleaning and hydrogen peroxide vapour decontamination. J Hosp Infect 2004;57:31-7.</li>
<li>Wilcox MH, Fawley WN, Wigglesworth N et al. Comparison of the effect of detergent versus hypochlorite cleaning on environmental contamination and incidence of Clostridium difficile infection. J Hosp Infect 2003;54:109-14. Erratum i: J Hosp Infect 2004;57:267.</li>
<li>Mayfield JL, Leet T, Miller J et al. Environmental control to reduce transmission of Clostridium difficile. Clin Infect Dis 2000;31:995-1000.</li>
<li>Denton M, Wilcox MH, Parnell P et al. Role of environmental cleaning in controlling an outbreak of Acinetobacter baumannii on a neurosurgical intensive care unit. J Hosp Infect 2004;56:106-10.</li>
<li>Byers KE, Durbin LJ, Simonton BM et al. Disinfection of hospital rooms contaminated with vancomycin-resistant Enterococcus faecium. Infect Control Hosp Epidemiol 1998;19:261-4.</li>
<li>Barker J, Vipond IB, Bloomfield SF. Effects of cleaning and disinfection in reducing the spread of Norovirus contamination via environmental surfaces. J Hosp Infect 2004;58:42-9.</li>
<li>Dancer SJ. How do we assess hospital cleaning? A proposal for microbiological standards for surface hygiene in hospitals. J Hosp Infect 2004; 56:10-5.</li>
<li>Griffith CJ, Cooper RA, Gilmore J et al. An evaluation of hospital cleaning regimes and standards. J Hosp Infect 2000;45:19-28.</li>
</ol>
Summary The importance of hygiene for hospital infections Ugeskr Læger 2007;169(49):4249-4251 Hospital cleaning is a neglected part of infection control. Due to financial constraints and lack of clinical evidence it has been cut down to the bare minimum and currently-used methods are unfit for the removal of microorganisms. Recent studies indicate that MRSA and other important pathogens may be transmitted to patients from the hospital environment. Furthermore, studies suggest that intensified cleaning may lower the risk of transmission. There is an urgent need for more clinical evidence and for development of standards and methods which focus on the removal of pathogens from the hospital environment.